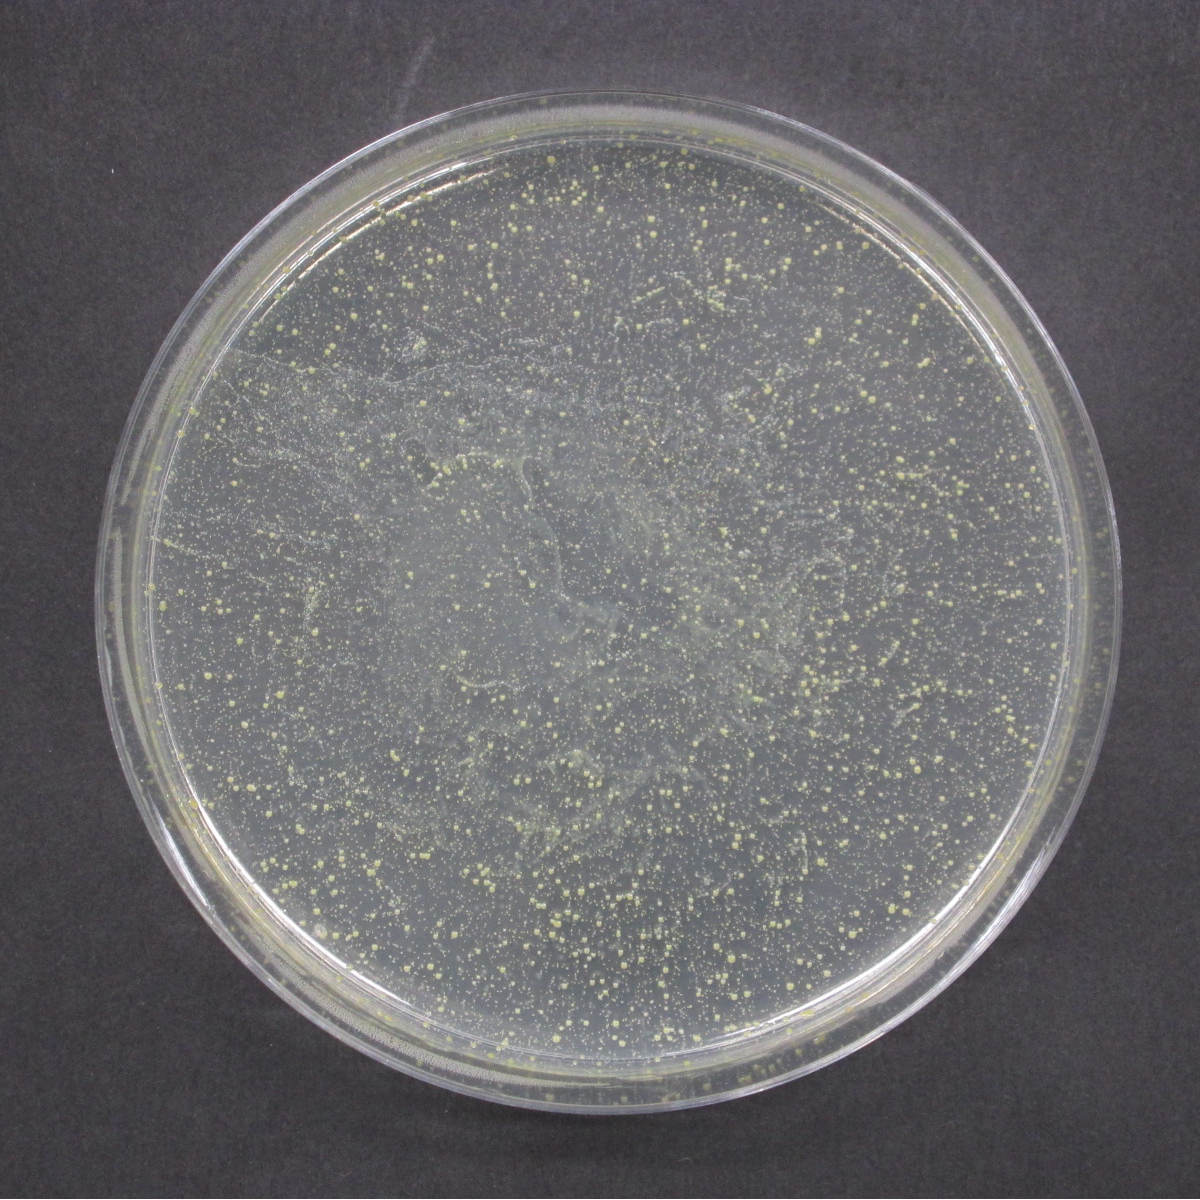

5/25
時点_ポイント最大13倍
leye 排水口カバー 抗菌ステンレス排水口カバー 直径14.5cm用 ( レイエ 食洗機対応 流し用 排水口 ふた 日本製 ステンレス 抗菌 銅イオン 排水フタ シンク キッチン用品 フタ キッチン 台所 排水口周り )
販売価格
2,860
円 (税込)
- 出荷目安:
- 1~3日で発送予定(休業日除く) ※急な在庫切れの際は、メールにて連絡します
たまるdポイント(通常) 26
+キャンペーンポイント(期間・用途限定) 最大12倍
※たまるdポイントはポイント支払を除く商品代金(税抜)の1%です。
※表示倍率は各キャンペーンの適用条件を全て満たした場合の最大倍率です。
各キャンペーンの適用状況によっては、ポイントの進呈数・付与倍率が最大倍率より少なくなる場合がございます。
dカードでお支払ならポイント3倍
各キャンペーンの適用状況によっては、ポイントの進呈数・付与倍率が最大倍率より少なくなる場合がございます。
- 商品情報
- レビュー

おすすめポイント


シンクを美しく見せる高品質カバー
燕三条の職人が丁寧に作り上げている高品質の排水口カバーです。排水口カバーと置き換えるだけの簡単設置で残菜などが詰まらずシンクを美しく見せます。またシンクに馴染みやすいデザインなので、見た目もアップグレードできます。


簡単交換で清潔な毎日
銅配合のステンレス素材でぬめりを軽減します。また、お手入れしやすいシンプルなデザインで食洗機にも対応しています。
商品詳細


4時間後に約98%の菌を抑制
排水口カバーに水が触れると銅イオンが溶けだし菌の増殖を抑制し、ぬめりを軽減します。4時間後には約98%の菌を抑制します。


小物が落ちにくい
カバー面が広く、スプーンやパッキンなどの小物が落ちにくくなります。また、無駄のない形状で食器を置くスペースが広がりシンクをゆったり使えます。


水切れの良いドーム型
ドーム型なので水切れがよくシンクを清潔に保てます。

ご注意点

※対応サイズにご注意下さい。
| サイズ | 約 高さ1.9(cm) 直径:約 14.4(cm) フチの高さ:約1.2cm |
| 重量 | 約 118g |
| 内容量 | 1個 |
| 材質 | ステンレス鋼(抗菌ステンレス) |
| 生産国 | 日本製 |
| 食器洗い乾燥機 | 使用可能 |
| 注意事項 | ※設置可能条件:排水口の直径が145mm、かつ蓋設置個所の段差が14mm以上 ※漂白剤使用不可 |
| 区分 | 返品・キャンセル区分(小型商品) ※北海道・沖縄・離島・一部山間部への配送は追加送料が発生する場合がございます。 |
あわせて買いたい
 排水口ネットホルダー |


関連キーワード:食洗機 OK 対応 ステンレス製 丈夫 排水カバー 止水カバー 清掃グッズ 清掃道具 清掃用品 そうじグッズ そうじ道具 そうじ用品 キッチン小物 キッチン雑貨 キッチンアイテム おすすめ オススメ 便利 役立つ シルバー
CODE/468962